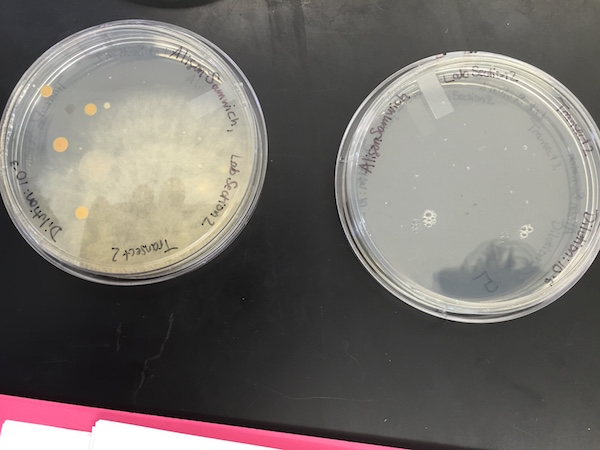
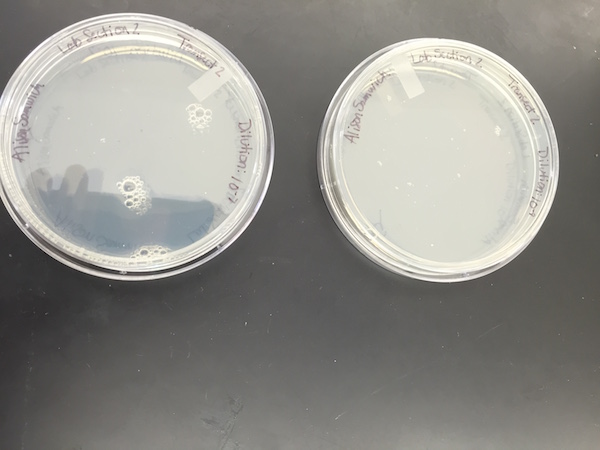
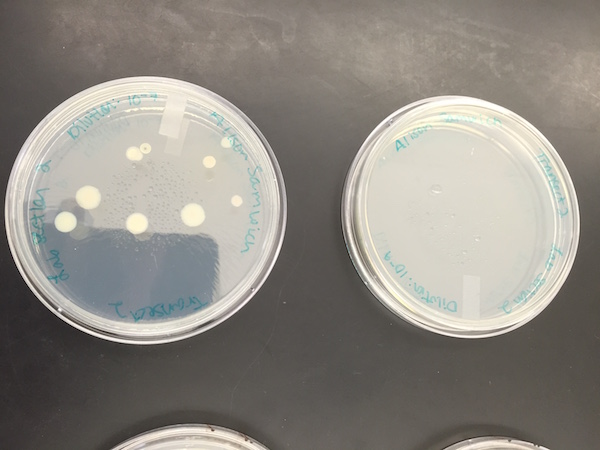
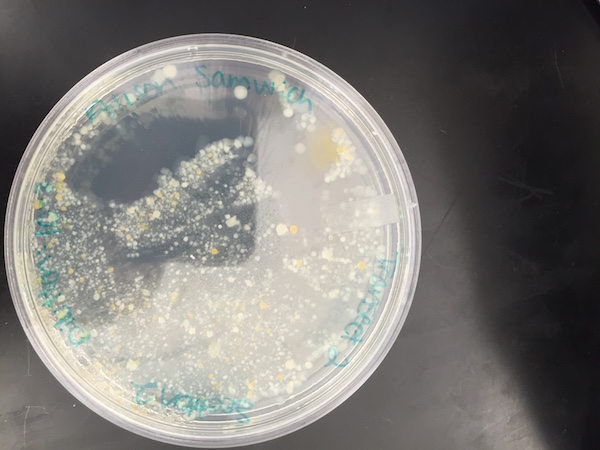
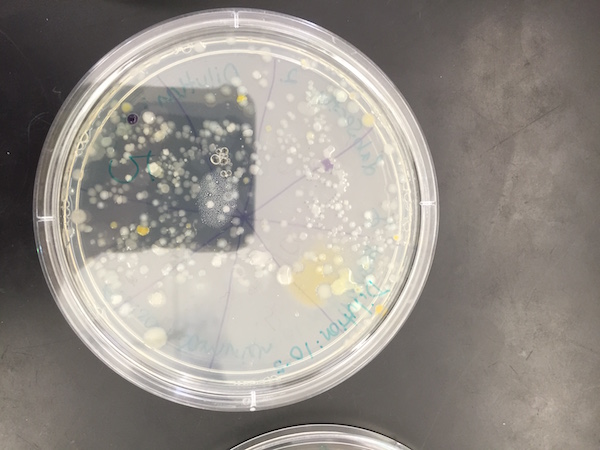

User:Alison M. Taylor/Notebook/Biology 210 at AU
Zebrafish Observation Week 2
March 2, 2016
The zebrafish were observed for a final time, then either fixed in formaldehyde or conglomerated to be moved to a new lab -- good luck, buddies!
Out of the 26 control fish, six had died by Monday of week two, and 14 of 26 had died by Wednesday of week two. 6 of the 26 were alive, of which three had been replaced at the very beginning of the experiment. Out of the 24 experimental fish, 1 had died by Monday of week 2, 17 died by Wednesday of week two, and six lived. The experimental fish therefore had a higher survival rate than the control fish. The fish that were alive were not very active at all -- only 2 showed any movement in each of the experimental and control groups.
Figure 1 Shows deceased fish collected in a tube.
Zebrafish Observation Week 1
February 24, 2016
Figure 1 Shows one of the control zebrafish under a compound microscope. Its eye measured about 10 um in length, and its body about 80 um, which were similar to the fish from the experimental group.
At one week, the fish had hatched and were fed shrimp so they could begin to learn to eat, and waste was removed from the dishes. Many more of the experimental fish had survived than the control fish. This was surprising because it was expected that if the epinephrine had an effect, it would be detrimental, but there were not yet any significant differences observed other than the increased survival rate. Two of the non surviving fish, one from each group, was anesthetized and then fixed in formaldehyde.
Embryo Development & Zebrafish Set up
February 17, 2016
Embryo comparison:
Figure 1: Shows the varying characteristics of starfish, frog, chick, and human embryos.
Zebrafish Experiment: On day one of the experiment, 12 zebrafish embryos were placed in 2 mL of DeerPark water. Another 12 were placed in 2 mL of Epinephrine. Epinephrine is also known as adrenaline and acts in the "fight or flight" response. If the fish are treated with epinephrine, then it is expected that observations will include behavioral differences and possibly physical conditions like increased heart rate. The embryos were 24 hours old, and somewhere around the 4-8 somites stage. On day three of the experiment, 11 of the zebrafish in the control dishes were observed to have not grown, and 1 of the experimental fish had not grown. These were replaced with new embryos, marked for identification.
Analyzing Invertebrates from the Berlese Funnel
February 10, 2016
Table 1: Shows data on the five invertebrates collected from transect 2.
The size ranged from microscopic arthropods to an earthworm about two inches long. The organism that was most frequently observed was in the phylum arthropoda and looked like an ant. The sample from the higher layer of the ethanol appeared to contain only these organisms. They were not observed in the second sample from the lower layer, which had less abundant but more diverse arthropods.
Vertebrates and Niches:
Five vertebrates that most likely live in transect 2 are:
1) Chordata Aves Passeriformes Turdidae Turdus T. migratorius (American Robin)
2) Chordata Aves Passeriformes Passeridae Passer P. domesticus (Sparrow)
3) Chordata Mammalia Rodentia Sciuridae Sciurini (Tree Squirrel)
4) Chordata Aves Passeriformes Cardinalidae Cardinalis C. Cardinalis (Cardinal)
5) Chordata Aves Columbiformes Columbidae Zenaida Z. macroura (Mourning Dove)
An abiotic feature of transect 2 which would benefit these animals is the readily available water. Biotic features include trees and well covered ground, which provide a good habitat for the birds and squirrels to live in. There are also plenty of invertebrates such as earthworms for the birds to feed on, even in the winter.
Fig 2: Shows a food web of the organisms present in transect 2
The organisms in this transect make up a community by interacting in a sustainable way. The transect has a smaller carrying capacity the higher up the food chain. While it can support countless small organisms like bacteria and protists, only a handful of squirrels and birds can be supported at any one time. Similarly, there are more organisms on the same trophic level lower down -- arthropods and bacteria are primary consumers, while the rarer birds and squirrels are secondary consumers.
Characterizing Plants from Transect 2
February 3, 2016
Plant collection and observation:
The condition of transect 2 was flooded as it was very rainy and around 48 F. The ground matter and debris were therefore very wet. The samples collected, shown below, were all angiosperms.
Fig. 1 Shows five plant samples selected from Transect 2.
Table 1 Shows characteristics of plant samples collected from the transect.
Observing Fungi:
Sporangia serve as the location for where spores are formed, which is how fungi reproduce, making sporangia vital.
Fig. 2 This sample in the lab is clearly a fungus due to the distinct characteristic of hyphae. This mushroom belongs to basidiomycota.
AMT
Observing Microorganisms via Morphology and Gram Staining
January 26, 2016
Hay Infusion Culture: Final Observation
The hay infusion culture has evaporated roughly an inch since the previous week. The plant matter has further decayed, leaving most of the water a little clearer. The water surface was perhaps more coagulated. The jar still smells like decay, and somewhat like feces. The smell and appearance may change week to week because the organic matter inside will have decomposed further as time goes on. Also, the growth of more bacteria and mold may add to the smell. There will not be any Archaea species growing in the culture though, as the conditions are not extreme enough.
Quantifying Microorganisms:
Table 1: Shows the number of colonies of bacteria grown on an agar plate with and without tetracycline, at various dilution levels.
The plates without tetracycline clearly grew many more bacteria than those with the antibiotic did. The most successful growth on a plate with tetracycline was that of mold, so antibiotic is less effective on fungi than bacteria (makes sense). The main kind of bacteria that grew on the non-antibiotic plates is the same type that showed up on the antibiotic plates. A few purple bacteria showed up on the non-antibiotic plates which did not grow at all on the tetracycline plates, indicating that the tetracycline has a greater effect on certain types of bacteria. None of the bacteria seemed to be totally unaffected by tetracycline though, given the lack of growth compared to non-tetracycline plates. The antibiotic Tetracycline hinders bacterial ribsomes from interacting with aminoacyle-tRNA, which prevents protein synthesis in the bacteria NCBI. Tetracycline affects bacteria including E. Coli, Streptococcal pneumoniae, and Bacillus anthracis (anthrax) Tulane PharmWiki
Cell Descriptions:
Table 2: Shows information about each of the four bacterial colonies observed
Figure 1: Drawings of each of the four colonies observed, at 40x magnification.
Figures 1-5: Photographs of all eight agar plates, showing the growth (or lack of) of bacteria and fungi on each.
Citations
Chopra, Ian, and Marilyn Roberts. “Tetracycline Antibiotics: Mode of Action, Applications, Molecular Biology, and Epidemiology of Bacterial Resistance.” Microbiology and Molecular Biology Reviews 65.2 (2001): 232–260. PMC. Web. 29 Jan. 2016.
AMT
Culture Observations and Serial Dilution
January 20, 2016
Figure 1: Serial dilution procedure using hay infusion culture and agar plates
Hay Infusion Culture Observations:
The hay infusion culture's appearance was swampy, clouded water, filled with organic debris. The smell was foul, distinctly like decomposition. There was no apparent life, except for possibly a small amount of mold growing on the jar right above the water line. A sample collected from the bottom revealed a colpidium (70um), paramacium (35um), and paranema (30um). A sample from nearer the top of the water contained volvox (400um), didinium (100um), and vorticella (50um). It is not surprising that this second sample contained protists, as they were drawn from near plant matter, which could serve as nutrition. Still, all six organisms observed were motile, nutrient-consuming protists.
The paramecium observed meets all fundamental characteristics of life. 1) Energy: paramecium acquire energy by consuming nutrients, like the dead plant matter in the hay infusion. 2) Cells: Paramecium are single-celled organisms. They have macronuclei, which are responsible for duties like digestion and protein synthesis. 3) Information: Paramecium's genetic information is replicated during binary fission or conjugation. 4) Replication: Paramecium replicate asexually through binary fission or sexually by conjugation. 5) Evolution: Paramecium's replication method of conjugation is an example of evolving to sexual dimorphism.
If the hay infusion culture was observed after another two months, I hypothesize that there would be more growth, as protists continued to eat decaying plant matter and reproduce, and algae, if any was present, continued to photosynthesize.
Figure 2: Protists observed from samples of hay infusion culture from transect 2.
Examining a Transect at AU & Hay Infusion Culture
January 13, 2016
Purpose: The purpose of this lab was to observe and collect samples from a 20x20ft transect, and then use the samples in a Hay Infusion Culture. This was done to enrich any microorganisms present in the sample. Our hypothesis is that there will be growth in the culture, particularly given that we included samples from still water, where there are likely to be living organisms.
Materials and Methods:
- Observe and draw aerial view of transect 2, just south of Hughes Hall on AU's campus.
- List abiotic and biotic components of the transect.
- Collect various samples, including soil, leaves, and water.
- In the laboratory, add 10.4g of sample ground matter and 6.5 mL of sampled water to a labeled plastic jar.
- Add 500 mL of room-temperature Deerpark water and .1g of dried milk to the jar.
- Cap the jar and shake to mix thoroughly.
- Take the lid off and let it sit for one week.
Data and Observations:
The transect sloped downwards to the west, in the direction the stream was flowing. The water flow was moderately paced, and the outer edges were still. The weather was 28F, sunny, and windy. The biotic components found in the transect were leaves, bushes, trees, plant bulbs, squirrels, and birds. The abiotic elements were rocks, trash (paper, glass bottles), an irrigation control box, water, and soil.
Figure 1: Aerial Drawing of transect 2.
Figure 2: Aerial picture of portion of transect 2.
Figure 3: Panoramic view of entire transect 2.
Conclusions and Future Directions:
So far there are no conclusions to be drawn, but it is known that some of the samples were abiotic and still living, despite the cold temperatures. Next week the Hay Infusion Culture will be observed to see if any protists are present.
AMT